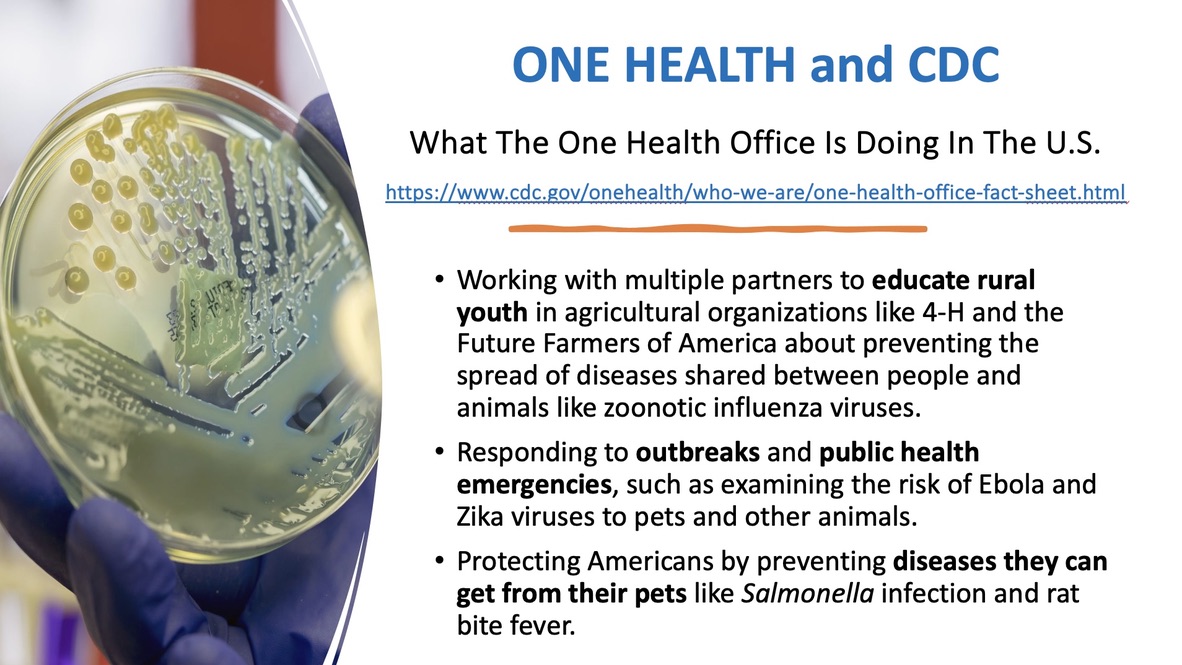

WHY is the One Health fantasy so important to Fauci and the globalists?
Another reason the pandemic origin had to be a natural zoonotic event--otherwise why give WHO power to control our ecosystems?
PPPR is a new acronym that stands for pandemic prevention, preparedness and response—as if anyone knows how to do any of these.
See, you connect all these things together and call it health, err, I mean One Health
All the big international, globalist organizations just love One Health:
CDC struggles trying to explain the importance of One Health, but CDC sure is enthusiastic about teaching everyone about it and spreading out a bit of $ to push the idea of One Health, even though it is really hard to explain how it benefits anything. Well, it might help save you from an infection caused by a bite from your pet rat or turtle. Maybe.
One Health is a major priority for the G20, as noted in the report of their meeting in New Delhi last month.
So with all that interest, what is One Health? Apparently the powers that be have struggled with defining it, and claim there are over 60 definitions. Let’s look at a few:
The OHHLEP is the One Health High Level Expert Panel, so be suitably impressed. It was created by 3 UN agencies and one independent agency: the WHO, Food and Agriculture Organization, the UN Environmental Program and the World Organization for Animal Health.
And if you understand the definition above, you are a better man than I. Oops, better watch my pronouns. Let’s try again with a different expert group’s definition of their task:
Got it? We are globalizing transformation in just about everything. I am certain that is a worthy goal for a Young Global Leader. By the way, while Klaus Schwab is GREAT at getting his Leaders installed in governments, none of them seem able to actually govern…at least not honestly. He has picked a bunch of good presenters, many of whom are easy on the eyes, but they lack depth, lack emotional range. Who are they, really? What do they stand for? Shallow puppets like Gavin Newsom, Justin Trudeau and Jacinda Ardern played their part, and they played it well, but they could not perform without a script…
Here is another meaningless attempt to describe what the action plan is for One Health is to do. It’s job is to Save the Planet. But how, exactly? There is never a real plan.
Well, if we can’t understand One Health, can we at least find out where it came from?
Even though it is meaningless, One Health is BIG, and it has been sent out around the world with zillions of One Health grants.
And the globalists know that you win through indoctrination of students. The three authors I circled below are all employees or contractors of EcoHealth Alliance—just in case you were not yet aware that the globalists have a limited bench and have to keep reusing their players. But what they write is still gobbledygook.
I wish it was only professional schools these evil apparachiks went after, but no, they want our kids from kindergarten on up.
The One Health basket just keeps growing. How many disparate areas can you toss into it?
Just in case you had not figured it out by now, One Health is the keys to the kingdom, the answer to society’s problems, and a ray of sunshine.
Here is a bunch more stuff that is included in One Health
But there is always a party pooper at every party. A few Chinese scientists venture to tell us the Emperor has no clothes. In very careful and difficult-to-comprehend language, of course.
Well that didn’t stop the One Health onslaught in the least. The Lancet just keeps those One Health articles coming. Now healthcare itself is polluting our world. One Health to the rescue!
But we all know this whole thing is total BS. As I stated in the European Parliament in May:
Is One Health the theoretical justification to reduce us to the level of animals? One Health needs to go. Far. AWAY.